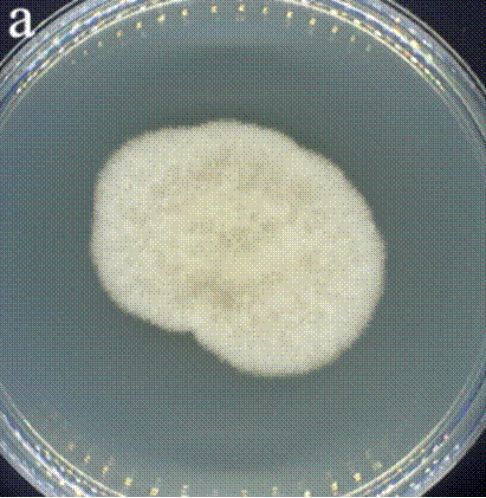

水果发霉了,切掉发霉部分还能吃吗?真相是...


发霉水果切掉坏的部分
剩下的真能吃吗?
很多人吃发霉水果
都习惯把坏的切掉继续吃
以为这样就安全了
但这个看似节约的习惯
可能正让你的健康“踩雷”!
事实上
霉变水果中可能会有
潜藏的真菌及其产生的有害毒素
01.
霉变的微观真相:
看不见的“菌丝网络”
肉眼可见的霉斑,只是真菌“冰山一角”——那是成熟后露出的繁殖结构。当你看到绒毛、粉末或色斑时,真菌早已发育成熟,孢子四散。而在表皮之下,无色透明的营养菌丝像根系般深深扎入果肉,悄然蔓延,肉眼根本无法察觉。

图片由AI生成
更大的隐患是真菌毒素。这些毒素多易溶于水,水果丰沛的汁液就成了它们无声的“运输网”。看似完好的果肉中,可能早已暗藏致病剂量的毒素。
正因水分会悄然携带毒素扩散,仅凭切除霉斑大小来判断安全,终究是靠不住的。
02.
水分——
真菌毒素扩散的加速器
水果中的水分不仅为霉菌提供了滋生条件,更充当了毒素扩散的“溶剂”和“载体”。一旦霉菌产生展青霉素、链格孢毒素等水溶性毒素,它们极易溶解于果实组织间的游离水中,并随着水分迁移而迅速渗透。即便霉斑仅显现于局部,毒素也可能在水分推动下,悄然蔓延至肉眼完好的果肉深处。
以苹果为例,质地虽相对致密,但感染扩展青霉后,强水溶性的展青霉素可在数厘米外的健康组织中检出。该毒素具有肾毒性,可致肠道损伤,长期摄入存在致畸和致癌风险。

青霉属菌落
番茄富含胶质水分,感染链格孢霉后,表皮出现黑色凹陷,其产生的链格孢毒素会迅速扩散,摄入可能引发呕吐、腹泻,并干扰内分泌,具潜在致癌性。
链格孢属菌落
草莓、葡萄等浆果组织松软、含水量高,极易被灰霉菌侵染,导致快速软烂。误食可能引发胃肠道不适,且霉菌孢子易飘散,诱发呼吸道过敏。
这些例子清晰地表明:霉变部位只是“冰山一角”,毒素的扩散范围远超肉眼所见。水果的质地虽然影响毒素初始渗透的速度,但由于高含水量的共性,一旦霉菌定植并产毒,毒素最终都有能力扩散至整个果实。
即便只是食用了那些已经切除霉变部分的“剩余好果”,实际上也仍然存在着摄入毒素的可能。
因此,即使切除霉变部分,仍可能摄入毒素。为规避急性中毒及长期肝肾损伤、致癌风险,对于所有高水分水果,一旦霉变,最安全的做法是整颗丢弃,切勿抱有侥幸心理。
实际上,极少数含水量极低、结构致密的果蔬,如胡萝卜和青椒,理论上切除霉斑周边2-5厘米后剩余部分可能是安全的。但日常生活中,仍不建议冒险尝试,因肉眼难以判断毒素渗透深度,切除过程也易造成交叉污染。
03.
常规煮沸杀不死的
“顽固毒素”
很多人以为“高温消毒”万能,觉得食物发霉后只要彻底加热就能安全食用,但这种观念其实隐藏着不小的健康风险。
事实上,霉菌产生的毒素种类繁多,其中许多化学性质极为稳定。常规的家庭烹饪,尤其是煮沸(通常不超过100℃),根本无法有效分解这些剧毒物质。
常见的高危毒素包括:强致癌的黄曲霉毒素;具肾毒性的赭曲霉毒素A;污染玉米的伏马菌素;引发剧烈呕吐的脱氧雪腐镰刀菌烯醇(呕吐毒素);影响生殖系统的玉米赤霉烯酮;以及存在于腐烂水果中的神经毒性展青霉素等。这些毒素均难以通过日常煮沸去除。

图片由AI生成
因此,一旦发现食物出现霉斑(如坚果上的黄绿色菌落)、斑块(如红薯上的褐色硬斑)、红心(如甘蔗芯发红)、腐烂(如水果变软)或发芽(如土豆),请务必牢记:
任何蒸、煮、炖、炸等常规加热方式,都无法确保消除其中潜藏的真菌毒素。
勤俭节约是美德
但节约的前提应是保障健康
面对霉变食物,与其冒险“抢救”
不如为家人多添一份安心
果断丢弃,不是浪费
而是对家人健康最切实的守护与负责

编辑:查艺宁
资料:中国疾控中心
*转载请注明来自上海杨浦官方微信
“上海杨浦”新媒体平台


求喜欢

特别声明:以上内容(如有图片或视频亦包括在内)为自媒体平台“网易号”用户上传并发布,本平台仅提供信息存储服务。
Notice: The content above (including the pictures and videos if any) is uploaded and posted by a user of NetEase Hao, which is a social media platform and only provides information storage services.
相关知识
年糕发霉,切掉霉变部分就能放心吃?千万要小心……
鱿鱼干发霉了还能吃吗 当心霉菌感染
白茶饼发霉了,发霉部分撬掉就行?别天真了,这样喝可不行!
水果面包发霉后,切除坏处还能吃吗?医生一次说清
年糕长白毛了还能吃,年糕发霉了还可以吃吗? – 百场汇
发霉的草莓能吃吗?发霉的草莓可以吃吗?
哈密瓜瓜蒂发霉长毛怎么办 还能吃吗
竹蒸笼发霉了洗不掉还能用吗
木耳发霉了还可以吃吗?木耳发霉了应该怎么办?
水果多久发霉
网址: 水果发霉了,切掉发霉部分还能吃吗?真相是... https://www.trfsz.com/newsview1907453.html
推荐资讯
- 1发朋友圈对老公彻底失望的心情 12775
- 2BMI体重指数计算公式是什么 11235
- 3补肾吃什么 补肾最佳食物推荐 11199
- 4性生活姿势有哪些 盘点夫妻性 10428
- 5BMI正常值范围一般是多少? 10137
- 6在线基础代谢率(BMR)计算 9652
- 7一边做饭一边躁狂怎么办 9138
- 8从出汗看健康 出汗透露你的健 9063
- 9早上怎么喝水最健康? 8613
- 10五大原因危害女性健康 如何保 7828
